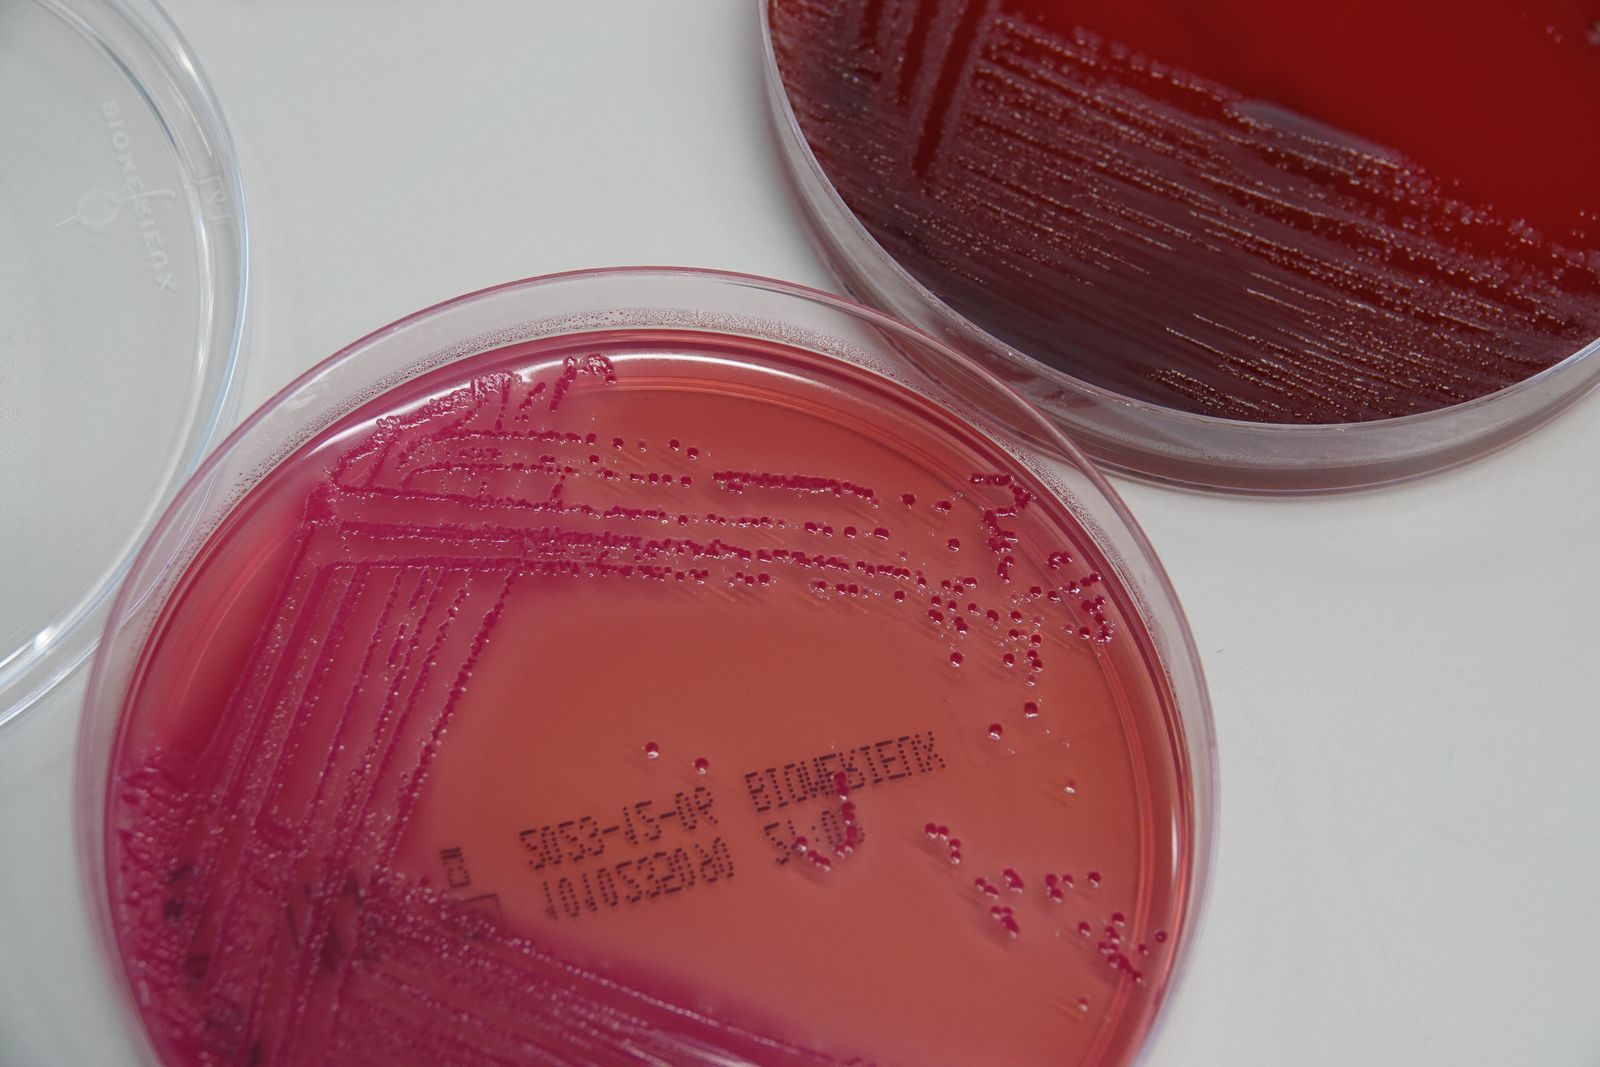
Исследование показывает, что кишечные микробы могут помочь в диагностике аутизма

Чашка Петри с бактериями из образца кала. Исследователи обнаружили ряд бактерий, грибков и вирусов в образцах кала детей, которые были изменены у детей с аутизмом.
Новое исследование обнаружило связь между определенными кишечными микробами и аутизмом у детей. Результаты показывают, что анализ кишечного микробиома может однажды помочь в диагностике аутизма, потенциально делая этот процесс намного быстрее и проще, сообщили исследователи в понедельник в журнале Природа Микробиология.
«Обычно требуется от трех до четырех лет, чтобы поставить подтвержденный диагноз при подозрении на аутизм, причем большинству детей диагноз ставится в возрасте шести лет», — говорит Ци Су, ведущий автор исследования и научный сотрудник Китайского университета Гонконга. ХранительЙен Сэмпл. «Наша панель биомаркеров микробиома показала высокую эффективность у детей в возрасте до четырех лет, что может способствовать ранней диагностике».
Су добавляет, что модель исследования должна быть проверена на более разнообразной группе детей, поскольку большинство детей в исследовании были из Гонконга. «Текущее исследование — это только начало долгого пути», — говорит он Газета «Нью-Йорк ТаймсТедди Розенблют.
Расстройство аутистического спектра — это нарушение развития, которое заставляет людей общаться, взаимодействовать и учиться иначе, чем нейротипичные люди, согласно данным Центров по контролю и профилактике заболеваний (CDC). Его причина неизвестна, хотя считается, что оно связано с генетическими и экологическими факторами, согласно исследованию.
Медицинского теста на аутизм не существует, поэтому его диагностика может быть сложной для врачей, которым приходится полагаться на поведение детей и субъективные отчеты родителей. Некоторые люди не диагностируются до подросткового или взрослого возраста и не получают лечения в более молодом возрасте.
Другие исследования показали, что может существовать связь между микробиомом кишечника и аутизмом. Предыдущие исследования показали, что фекальные трансплантаты, полученные от нейротипичных людей людям с аутизмом, улучшили их симптомы. Но большая часть работы была сосредоточена в основном на бактериальном компоненте микробиома, оставляя без ответа вопросы о том, влияют ли аутизм на археи, грибки, вирусы или функции кишечника, пишут авторы исследования.
Для новой статьи исследователи изучили 1627 детей в возрасте от 1 до 13 лет, как с аутизмом, так и без него. Они обнаружили, что у детей с аутизмом были изменены 14 архей, 51 бактерия, 7 грибков, 18 вирусов, 27 микробных генов и 12 метаболических путей. Затем исследователи использовали инструменты машинного обучения для выявления детей с аутизмом на основе их кишечных микробов с точностью до 82 процентов, согласно Хранитель.
«Результаты в целом соответствуют предыдущим исследованиям, которые показывают снижение микробного разнообразия у аутичных людей. Также изучается одна из самых больших выборок, наблюдаемых в подобных исследованиях, что еще больше подкрепляет результаты», — говорится в заявлении Science Media Center, Бхишмадев Чакрабарти, директор по исследованиям Центра аутизма в Университете Рединга в Англии. «Одним из ограничений этих данных является то, что они не могут оценить какую-либо причинную роль микробиоты в развитии аутизма».
Рано Согласно статье, диагностика аутизма может привести к лучшим социальным и поведенческим результатам. Новые результаты могут проложить путь к диагностическим тестам на аутизм, которые используют образцы стула, содержащие информацию о микробиоме кишечника.
Элизабет Ланд, независимый консультант по вопросам питания и здоровья желудочно-кишечного тракта, которая не принимала участия в выводах, называет эту идею «очень захватывающей» в заявлении Science Media Center. «Текущий (диагностический) процесс очень длительный, и ощущается нехватка врачей, таких как психологи и психиатры, обученных проводить надлежащую диагностику», — добавляет она. «Очевидно, что исследование необходимо повторить с другими группами и среди других популяций по всему миру, но этот подход может предложить новый и более автоматизированный путь к диагностике в долгосрочной перспективе».
Некоторые исследователи также утверждают, что любые различия в микробиоме кишечника у людей с аутизмом могут быть вызваны их рационом питания. В новом исследовании команда обнаружила, что, хотя рацион питания и влиял на микробиом кишечника детей с аутизмом, различия в их микробиомах сохранялись даже после учета диетических изменений.
«Ветер меняется», — говорит микробиолог из Нью-Йоркского университета Гаспар Тарончер-Ольденбург, изучающий связи между кишечными микробами и аутизмом. Газета «Нью-Йорк Таймс«Люди теперь признают, что микробиом — это не просто часть всего этого, но он может быть фундаментальной частью головоломки».